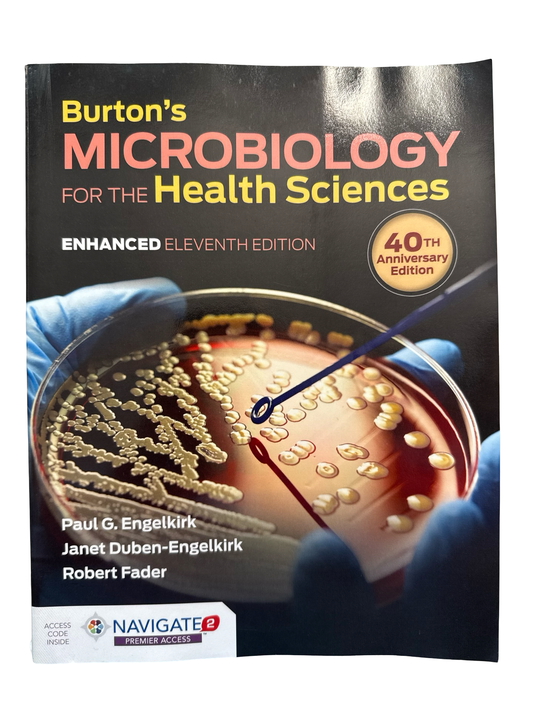
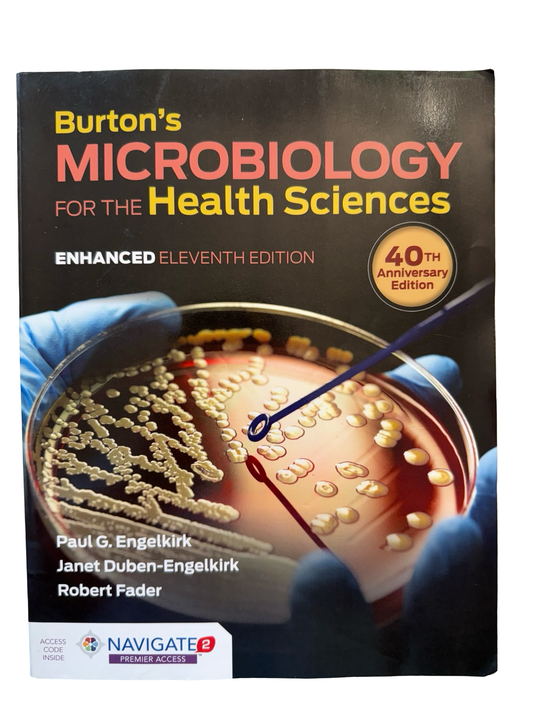

-
 Sold out
Sold outMedical terminology a short course
Regular price $40.00 CADRegular priceUnit price per -
 Sold out
Sold outMedical terminology a short course
Regular price $45.00 CADRegular priceUnit price per -
Medical Terminology Learning Through Practice
Regular price $40.00 CADRegular priceUnit price per -
Medical Terminology Learning Through Practice
Regular price $60.00 CADRegular priceUnit price per -
Medical Terminology Learning through practice Second Edition
Regular price $80.00 CADRegular priceUnit price per -
 Sold out
Sold outMedical Terminology short course
Regular price $60.00 CADRegular priceUnit price per -
Medical-Surgical Nursing In Canada, LEWIS'S Fifth Edition
Regular price $100.00 CADRegular priceUnit price per -
Medical-Surgical Nursing In Canada, Lewis's, Fifth Edition
Regular price $100.00 CADRegular priceUnit price per -
Medium/Heavy Duty Truck Engines,Fuel &Computerized Management Systems
Regular price $130.00 CADRegular priceUnit price per -
 Sold out
Sold outMental Health Awareness bundle
Regular price $70.00 CADRegular priceUnit price per -
Mental Health Awareness for First Responders
Regular price $80.00 CADRegular priceUnit price per -
Mental Health Awareness for First Responders
Regular price $80.00 CADRegular priceUnit price per -
Mental Health Awareness for First Responders 2nd edition
Regular price $70.00 CADRegular priceUnit price per -
Mental Health Awareness for first responders bundle
Regular price $75.00 CADRegular priceUnit price per -
Mental health awareness for First Responders Bundle 2nd edition
Regular price $75.00 CADRegular priceUnit price per -
Mental Health Awareness For first responders Bundle Second Edition
Regular price $80.00 CADRegular priceUnit price per -
Mental Health Awareness for the First Responders bundle
Regular price $100.00 CADRegular priceUnit price per -
MENTAL HEALTH SELF-CARE FOR FIRST RESPONDERS SECOND EDITION
Regular price $110.00 CADRegular priceUnit price per -
Microbiology for the Health Sciences
Regular price $80.00 CADRegular priceUnit price per -
Microbiology for the Health Sciences Enhanced 11 th ed
Regular price $75.00 CADRegular priceUnit price per -
Microbiology Fundamentals
Regular price $30.00 CADRegular priceUnit price per -
Microbiology with Diseases by Taxonomy
Regular price $120.00 CADRegular priceUnit price per -
Microeconomics For Life second ed loose leaf
Regular price $60.00 CADRegular priceUnit price per -
Modelling the Environment
Regular price $35.00 CADRegular priceUnit price per -
Modern Cabinet Making
Regular price $110.00 CADRegular priceUnit price per -
Modern Diesel Technology Electricity and Electronics 2 nd ed
Regular price $150.00 CADRegular priceUnit price per -
Modern Metal working 10 edition
Regular price $120.00 CADRegular priceUnit price per -
 Sold out
Sold outModern Metal Working 11th edition
Regular price $130.00 CADRegular priceUnit price per -
Modern Plumbing lab workbook 9th edition
Regular price $45.00 CADRegular priceUnit price per -
 Sold out
Sold outModern Plumbing Ninth edition
Regular price $180.00 CADRegular priceUnit price per -
 Sold out
Sold outModern Welding
Regular price $140.00 CADRegular priceUnit price per -
Morrison-Valfre’s FOUNDATIONS of MENTAL HEALTH CARE in CANADA
Regular price $55.00 CADRegular priceUnit price per -
Motor Controls and Programmable Logic Controls (st Clair College ed )
Regular price $35.00 CADRegular priceUnit price per -
MULHOLLAND'S The NURSE, The MATH, The MEDS 5th Edition
Regular price $60.00 CADRegular priceUnit price per -
MULHOLLAND'S The Nurse, The Math, The Meds Drug Calculations Using Dimensional Analysis 5th edition
Regular price $55.00 CADRegular priceUnit price per -
Nancy Carolines Emergency Care on the Streets with unused Access Code
Regular price $400.00 CADRegular priceUnit price per